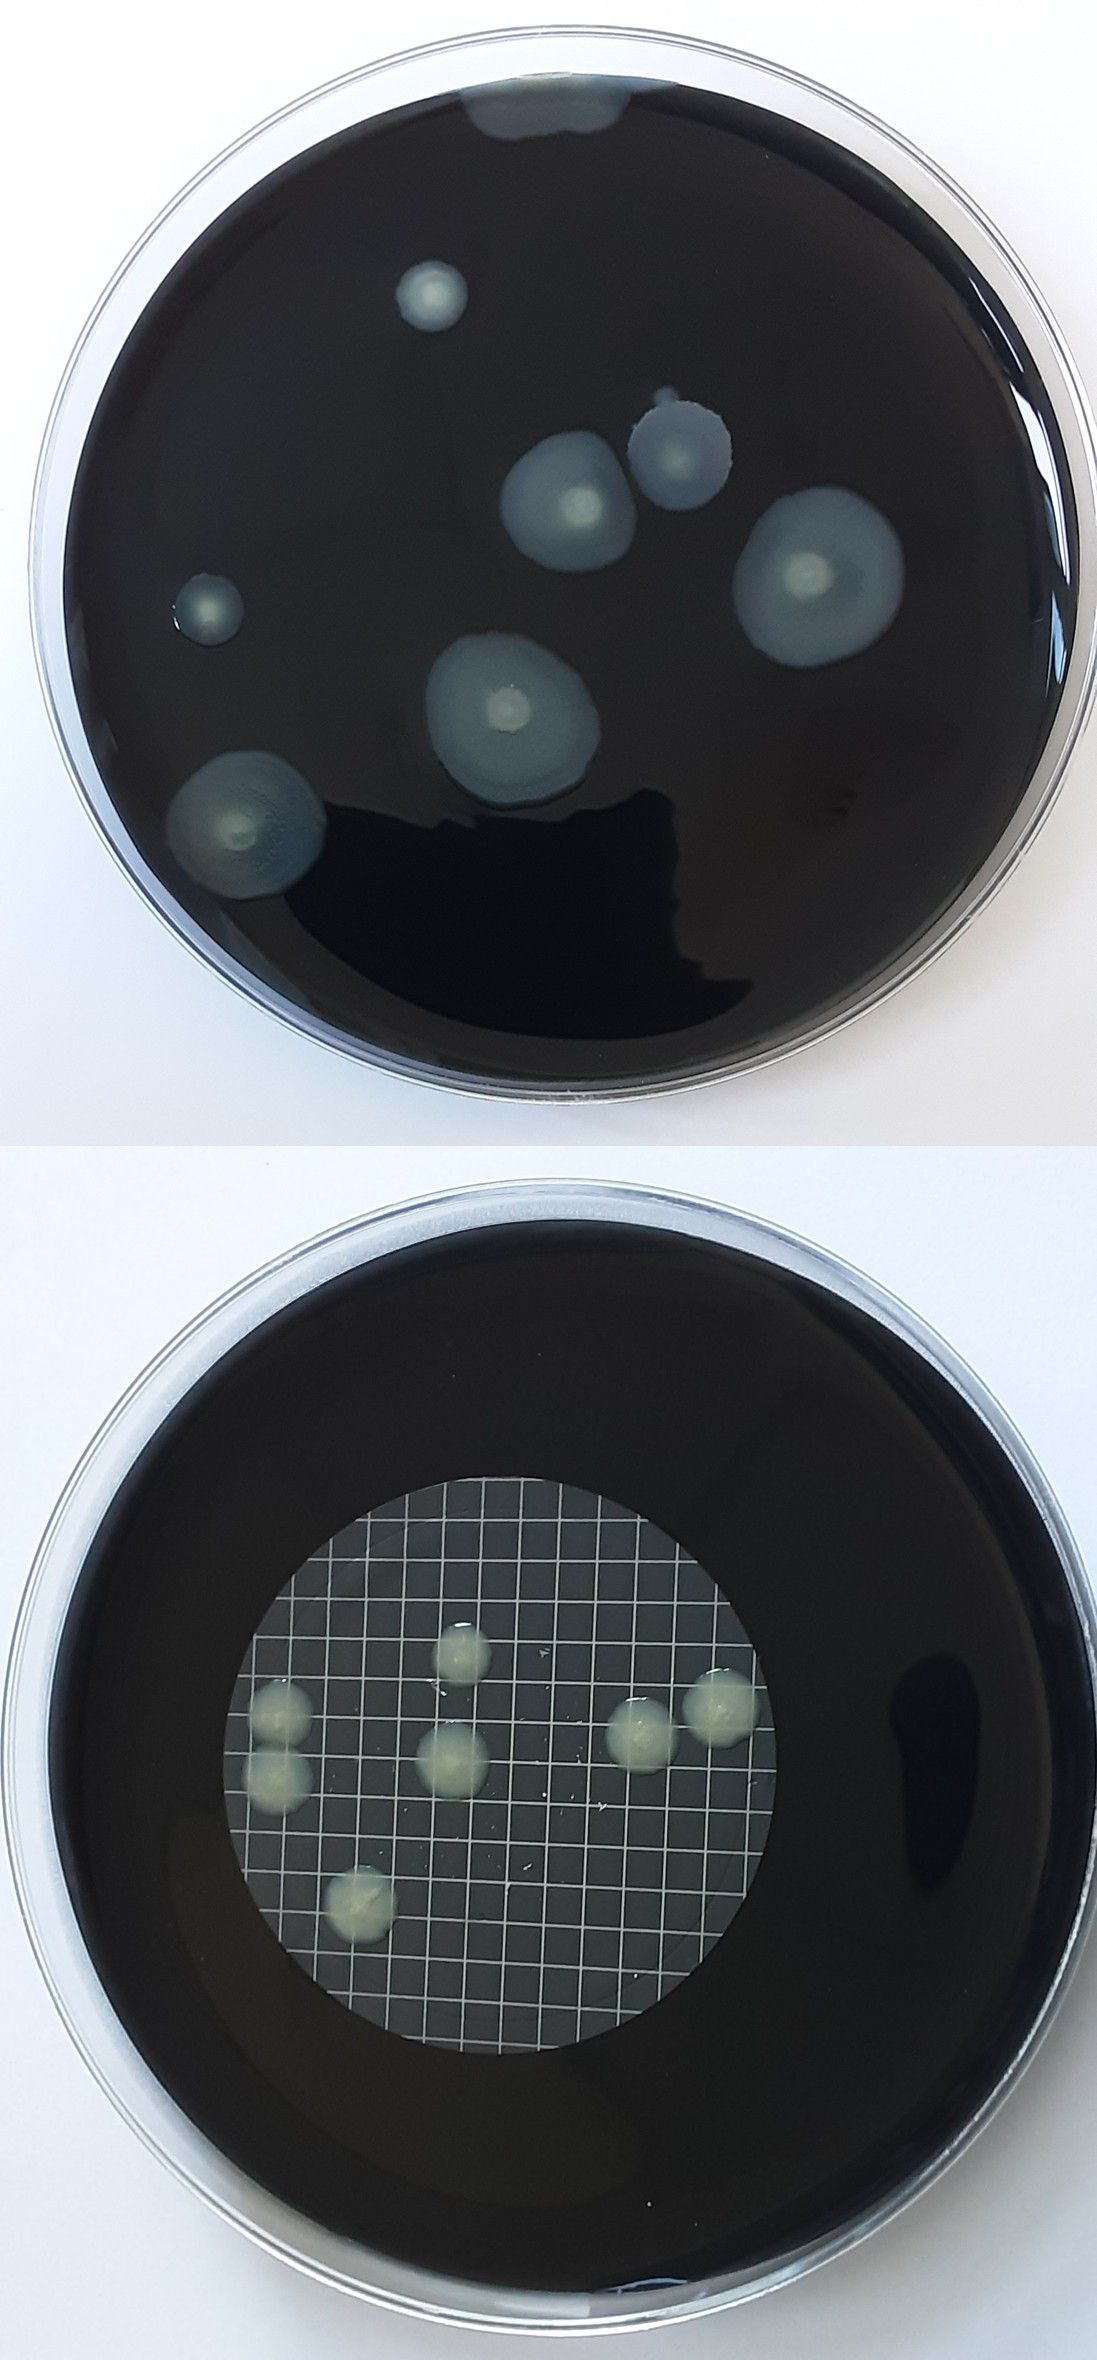
Zwei dunkle Petrischalen, eine mit verstreuten hellen Kolonien und eine mit einem gitterartigen Muster auf der Unterseite.

Legionellenprüfung im Trinkwasser
Gesetzlich vorgeschriebene Untersuchungen für Warmwasserversorgungsanlagen
Die Überprüfung von Trinkwasser auf Legionellen ist eine gesetzlich vorgeschriebene Pflichtuntersuchung gemäß Trinkwasserverordnung. Besonders betroffen sind Warmwasserversorgungsanlagen in gewerblich oder öffentlich genutzten Gebäuden, in denen es zur Vernebelung von Wasser kommen kann – beispielsweise durch Duschen. Die LWU GmbH führt fachgerechte Probenahmen und Laboranalysen durch und unterstützt Betreiber bei der Einhaltung aller gesetzlichen Vorgaben. Unsere Untersuchungen erfolgen nach akkreditierten Verfahren und liefern verlässliche, behördlich anerkannte Ergebnisse. Wir beraten Sie umfassend zu Prüfpflichten, Intervallen und Maßnahmen bei auffälligen Befunden.
Legionellenprüfung und Bewertung der Ergebnisse
Wir übernehmen die vollständige Untersuchung Ihrer Anlage – von der Probenahme bis zur Bewertung der Ergebnisse gemäß den geltenden gesetzlichen Vorgaben und Richtlinien.
Systemische Untersuchung von Warmwasseranlagen
Wir prüfen Trinkwasser-Installationen auf Legionellen, um mögliche Belastungen frühzeitig zu erkennen und zu bewerten.
Fachgerechte Probenahme an relevanten Entnahmestellen
Die Proben werden an allen vorgeschriebenen Stellen entnommen, um eine vollständige und normgerechte Bewertung der Anlage sicherzustellen.
Analyse nach Trinkwasserverordnung
Die Untersuchung erfolgt gemäß den gesetzlichen Anforderungen und berücksichtigt alle relevanten mikrobiologischen Parameter.
Bewertung nach Grenz- und Maßnahmenwerten
Die Ergebnisse werden anhand des technischen Maßnahmewertes bewertet, um notwendige Schritte klar abzuleiten.
Unterstützung bei Maßnahmen und Meldepflichten
Bei auffälligen Befunden unterstützen wir Sie bei der Einleitung notwendiger Maßnahmen und der Kommunikation mit Behörden.
Häufige Fragen zur Legionellenprüfung
Wann ist eine Legionellenprüfung vorgeschrieben?
Eine Untersuchung ist erforderlich, wenn es sich um eine Großanlage zur Trinkwassererwärmung handelt und das Wasser im Rahmen einer gewerblichen oder öffentlichen Tätigkeit abgegeben wird. Dazu zählen beispielsweise Mehrfamilienhäuser, Krankenhäuser oder Hotels. Ein- und Zweifamilienhäuser sind in der Regel nicht betroffen.
Wie oft muss eine Untersuchung durchgeführt werden?
Die Prüfintervalle hängen von der Nutzung der Anlage ab. In Wohngebäuden erfolgt die Untersuchung in der Regel alle drei Jahre, während in gewerblichen oder öffentlichen Einrichtungen häufig jährliche Prüfungen erforderlich sind. Das zuständige Gesundheitsamt legt die genauen Fristen fest.
Wo werden die Wasserproben entnommen?
Die Probenahme erfolgt an mehreren festgelegten Stellen innerhalb der Anlage, darunter am Speicher, im Rücklauf sowie an den entferntesten Entnahmestellen. Voraussetzung sind geeignete Entnahmeventile, die gegebenenfalls nachgerüstet werden müssen. Die Entnahme erfolgt durch geschultes Fachpersonal.
Wer darf die Proben entnehmen und untersuchen?
Nur ein zugelassenes Labor mit entsprechend geschultem Personal darf Wasserproben für offizielle Untersuchungen entnehmen und analysieren. Dies ist notwendig, damit die Ergebnisse von Behörden anerkannt werden. Die LWU GmbH erfüllt alle erforderlichen Voraussetzungen.
Was passiert bei erhöhten Legionellenwerten?
Wird der technische Maßnahmewert überschritten, sind gestaffelte Maßnahmen erforderlich – von zusätzlichen Untersuchungen bis hin zu technischen Maßnahmen zur Gefahrenabwehr. Zudem besteht eine Meldepflicht gegenüber dem Gesundheitsamt. Wir unterstützen Sie bei der Bewertung und den nächsten Schritten.
Welche Grenzwerte gibt es für Legionellen?
Es gibt einen technischen Maßnahmewert. Je nach Höhe der Belastung müssen zusätzliche Untersuchungen, technische Maßnahmen oder weiterführende Analysen durchgeführt werden. Die Bewertung erfolgt nach klar definierten gesetzlichen Vorgaben.
